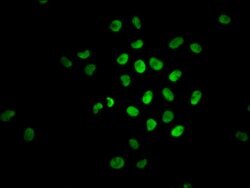
Invitrogen Phospho-Nrf2 (Ser40) Recombinant Rabbit Monoclonal Antibody

missing translation for 'onlineSavingsMsg'
Learn More
Learn More
Invitrogen™ Phospho-Nrf2 (Ser40) Recombinant Rabbit Monoclonal Antibody (2E6)


Rabbit Recombinant Monoclonal Antibody
Brand: Invitrogen™ MA533211
This item is not returnable.
View return policy
Description
Phospho-Nrf2 (Ser40) Recombinant Monoclonal Antibody for Western Blot, ICC/IF, IHC (P), ELISA
Nfr1 (also designated TCF11), Nrf2 and Nfr3 are bZIP transcription factors that heterodimer with Maf proteins to bind MARE (Maf recognition elements) sequences. Nrf2 is widely expressed and is thought to translocate to the nucleus after treatment with xenobiotics and antioxidants, which stimulate its release from a repressor protein Keap1.
Specifications
| Phospho-Nrf2 (Ser40) | |
| Recombinant Monoclonal | |
| 0.5 mg/mL | |
| PBS with 0.05% BSA, 50% glycerol and 0.02% sodium azide; pH 7.4 | |
| Q16236 | |
| NFE2L2 | |
| A synthesized peptide derived from human Phospho-NFE2L2 (S40). | |
| 100 μL | |
| Primary | |
| Human | |
| Antibody | |
| IgG |
| ELISA, Immunohistochemistry (Paraffin), Western Blot, Immunocytochemistry | |
| 2E6 | |
| Unconjugated | |
| NFE2L2 | |
| AI194320; E4TF1-60; E4TF1A; HEBP1; Nfe2l2; NF-E2-related factor 2; NFE2-related factor 2; NF-E2-related factor-2; NFT2; NRF2; NRF2A; nuclear factor (erythroid-derived 2)-like 2; nuclear factor erythroid 2-like 2; nuclear factor erythroid 2-related factor 2; nuclear factor erythroid-derived 2-like 2; nuclear factor, erythroid 2 like 2; nuclear factor, erythroid 2-like 2; nuclear factor, erythroid derived 2, like 2; Unknown (protein for IMAGE:7945830) | |
| Rabbit | |
| Affinity chromatography | |
| RUO | |
| 4780 | |
| -20°C or -80°C if preferred | |
| Liquid |
Product Content Correction
Your input is important to us. Please complete this form to provide feedback related to the content on this product.
Product Title
Spot an opportunity for improvement?Share a Content Correction